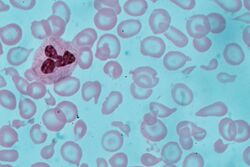

Anemia
 From Handwiki
From Handwiki
| Anemia | |
|---|---|
| Other names | Anaemia, erythrocytopenia |
 | |
| Blood smear showing iron-deficiency anemia, with small, pale red blood cells. | |
| Pronunciation |
|
| Specialty | Hematology |
| Symptoms | Feeling tired, pale skin, weakness, shortness of breath, feeling faint[1] |
| Causes | Blood loss, decreased red blood cell production, increased red blood cell breakdown[1] |
| Diagnostic method | Blood hemoglobin measurement[1] |
| Frequency | 2.36 billion / 33% (2015)[2] |
Anemia or anaemia (British English) is a blood disorder in which the blood has a reduced ability to carry oxygen due to a lower than normal number of red blood cells, a reduction in the amount of hemoglobin or hemoglobin abnormalities.[3][4] The name is derived from Ancient Greek: Script error: The function "transl" does not exist., meaning 'lack of blood', from ἀν- Script error: The function "transl" does not exist., 'not' and αἷμα Script error: The function "transl" does not exist., 'blood'.[5] When anemia comes on slowly, the symptoms are often vague, such as tiredness, weakness, shortness of breath, headaches, and a reduced ability to exercise.[1] When anemia is acute, symptoms may include confusion, feeling like one is going to pass out, loss of consciousness, and increased thirst.[1] Anemia must be significant before a person becomes noticeably pale.[1] Symptoms of anemia depend on how quickly hemoglobin decreases.[4] Additional symptoms may occur depending on the underlying cause.[1] Preoperative anemia can increase the risk of needing a blood transfusion following surgery.[6] Anemia can be temporary or long term and can range from mild to severe.[7]
Anemia can be caused by blood loss, decreased red blood cell production, and increased red blood cell breakdown.[1] Causes of bleeding include bleeding due to inflammation of the stomach or intestines, bleeding from surgery, serious injury, or blood donation.[1] Causes of decreased production include iron deficiency, vitamin B12 deficiency, thalassemia and a number of bone marrow tumors.[1] Causes of increased breakdown include genetic disorders such as sickle cell anemia, infections such as malaria, and certain autoimmune diseases.[1] Anemia can also be classified based on the size of the red blood cells and amount of hemoglobin in each cell.[1] If the cells are small, it is called microcytic anemia; if they are large, it is called macrocytic anemia; and if they are normal sized, it is called normocytic anemia.[1] The diagnosis of anemia in men is based on a hemoglobin of less than 130 to 140 g/L (13 to 14 g/dL); in women, it is less than 120 to 130 g/L (12 to 13 g/dL).[1][8] Further testing is then required to determine the cause.[1][9]
A large number of patients diagnosed with anemia of chronic disease present with no active inflammation or dietary issues. These include many with reduced limb loading, such as spinal cord injured patients, astronauts, elderly people with limited mobility, bed-bound and experimental bed-rest subjects.[10]
Certain groups of individuals, such as pregnant women, benefit from the use of iron pills for prevention.[1][11] Dietary supplementation, without determining the specific cause, is not recommended.[1] The use of blood transfusions is typically based on a person's signs and symptoms.[1] In those without symptoms, they are not recommended unless hemoglobin levels are less than 60 to 80 g/L (6 to 8 g/dL).[1][12] These recommendations may also apply to some people with acute bleeding.[1] Erythropoiesis-stimulating agents are only recommended in those with severe anemia.[12]
Anemia is the most common blood disorder, affecting about a fifth to a third of the global population.[1][2][13][14] Iron-deficiency anemia affects nearly 1 billion people.[15] In 2013, anemia due to iron deficiency resulted in about 183,000 deaths – down from 213,000 deaths in 1990.[16] This condition is most prevalent in children[17] with also an above average prevalence in elderly[1] and women of reproductive age (especially during pregnancy).[15]
Anemia is one of the six WHO global nutrition targets for 2025 and for diet-related global targets endorsed by World Health Assembly in 2012 and 2013. Efforts to reach global targets contribute to reaching Sustainable Development Goals (SDGs),[18] with anemia as one of the targets in SDG 2 for achieving zero world hunger.[19]
Signs and symptoms


A person with anemia may not have any symptoms, depending on the underlying cause, and no symptoms may be noticed, as the anemia is initially mild, and then the symptoms become worse as the anemia worsens. A patient with anemia may report feeling tired, weak, decreased ability to concentrate, and sometimes shortness of breath on exertion.[21] These symptoms are unspecific and none of the symptoms alone or in combination show a good predictive value for the presence of anemia in non-clinical patients.[22]

Symptoms of anemia can come on quickly or slowly.[23] Early on there may be few or no symptoms.[23] If the anemia continues slowly (chronic), the body may adapt and compensate for this change. In this case, no symptoms may appear until the anemia becomes more severe.[20][24] Symptoms can include feeling tired, weak, dizziness, headaches, intolerance to physical exertion, shortness of breath, difficulty concentrating, irregular or rapid heartbeat, cold hands and feet, cold intolerance, pale or yellow skin, poor appetite, easy bruising and bleeding, and muscle weakness.[23] Anemia that develops quickly, often, has more severe symptoms, including, feeling faint, chest pain, sweating, increased thirst, and confusion.[23] There may be also additional symptoms depending on the underlying cause.[1]
In more severe anemia, the body may compensate for the lack of oxygen-carrying capability of the blood by increasing cardiac output. The person may have symptoms related to this, such as palpitations, angina (if pre-existing heart disease is present), intermittent claudication of the legs, and symptoms of heart failure.[25]
On examination, the signs exhibited may include pallor (pale skin, mucosa, conjunctiva and nail beds), but this is not a reliable sign. A blue coloration of the sclera may be noticed in some cases of iron-deficiency anemia.[26] There may be signs of specific causes of anemia, e.g. koilonychia (in iron deficiency), jaundice (when anemia results from abnormal break down of red blood cells – in hemolytic anemia), nerve cell damage (vitamin B12 deficiency), bone deformities (found in thalassemia major) or leg ulcers (seen in sickle-cell disease). In severe anemia, there may be signs of a hyperdynamic circulation: tachycardia (a fast heart rate), bounding pulse, flow murmurs, and cardiac ventricular hypertrophy (enlargement). There may be signs of heart failure. Pica, the consumption of non-food items such as ice, paper, wax, grass, hair or dirt, may be a symptom of iron deficiency;[27] although it occurs often in those who have normal levels of hemoglobin. Chronic anemia may result in behavioral disturbances in children as a direct result of impaired neurological development in infants, and reduced academic performance in children of school age. Restless legs syndrome is more common in people with iron-deficiency anemia than in the general population.[28]
Causes

The causes of anemia may be classified as impaired red blood cell (RBC) production, increased RBC destruction (hemolytic anemia), blood loss and fluid overload (hypervolemia). Several of these may interplay to cause anemia. The most common cause of anemia is blood loss, but this usually does not cause any lasting symptoms unless a relatively impaired RBC production develops, in turn, most commonly by iron deficiency.[4]
Impaired production
- Disturbance of proliferation and differentiation of stem cells
- Pure red cell aplasia[30]
- Aplastic anemia[30] affects all kinds of blood cells. Fanconi anemia is a hereditary disorder or defect featuring aplastic anemia and various other abnormalities.
- Anemia of kidney failure[30] due to insufficient production of the hormone erythropoietin
- Anemia of endocrine disease[31]
- Disturbance of proliferation and maturation of erythroblasts
- Pernicious anemia[30] is a form of megaloblastic anemia due to vitamin B12 deficiency dependent on impaired absorption of vitamin B12. Lack of dietary B12 causes non-pernicious megaloblastic anemia.
- Anemia of folate deficiency,[30] as with vitamin B12, causes megaloblastic anemia
- Anemia of prematurity, by diminished erythropoietin response to declining hematocrit levels, combined with blood loss from laboratory testing, generally occurs in premature infants at two to six weeks of age.
- Iron-deficiency anemia, resulting in deficient heme synthesis[30]
- Thalassemias, causing deficient globin synthesis[30]
- Congenital dyserythropoietic anemias, causing ineffective erythropoiesis
- Anemia of kidney failure[30] (also causing stem cell dysfunction)
- Other mechanisms of impaired RBC production
- Myelophthisic anemia[30] or myelophthisis is a severe type of anemia resulting from the replacement of bone marrow by other materials, such as malignant tumors, fibrosis, or granulomas.
- Myelodysplastic syndrome[30]
- anemia of chronic inflammation[30]
- Leukoerythroblastic anemia is caused by space-occupying lesions in the bone marrow that prevent normal production of blood cells.[32]
Increased destruction
Anemias of increased red blood cell destruction are generally classified as hemolytic anemias. These types generally feature jaundice, and elevated levels of lactate dehydrogenase.[33][34]
- Intrinsic (intracorpuscular) abnormalities[30] cause premature destruction. All of these, except paroxysmal nocturnal hemoglobinuria, are hereditary genetic disorders.[35]
- Hereditary spherocytosis[30] is a hereditary defect that results in defects in the RBC cell membrane, causing the erythrocytes to be sequestered and destroyed by the spleen.
- Hereditary elliptocytosis[30] is another defect in membrane skeleton proteins.
- Abetalipoproteinemia,[30] causing defects in membrane lipids
- Enzyme deficiencies
- Pyruvate kinase and hexokinase deficiencies,[30] causing defect glycolysis
- Glucose-6-phosphate dehydrogenase deficiency and glutathione synthetase deficiency,[30] causing increased oxidative stress
- Hemoglobinopathies
- Sickle cell anemia[30]
- Hemoglobinopathies causing unstable hemoglobins[30]
- Paroxysmal nocturnal hemoglobinuria[30]
- Extrinsic (extracorpuscular) abnormalities
- Antibody-mediated
- Warm autoimmune hemolytic anemia is caused by autoimmune attack against red blood cells, primarily by IgG. It is the most common of the autoimmune hemolytic diseases.[36] It can be idiopathic, that is, without any known cause, drug-associated or secondary to another disease such as systemic lupus erythematosus, or a malignancy, such as chronic lymphocytic leukemia.[37]
- Cold agglutinin hemolytic anemia is primarily mediated by IgM. It can be idiopathic[38] or result from an underlying condition.
- Rh disease,[30] one of the causes of hemolytic disease of the newborn
- Transfusion reaction to blood transfusions[30]
- Mechanical trauma to red blood cells
- Microangiopathic hemolytic anemias, including thrombotic thrombocytopenic purpura and disseminated intravascular coagulation[30]
- Infections, including malaria[30]
- Heart surgery
- Haemodialysis
- Parasitic
- Trypanosoma congolense alters the surfaces of RBCs of its host and this may explain T. c. induced anemia[39]
- Antibody-mediated
Blood loss
- Anemia of prematurity, from frequent blood sampling for laboratory testing, combined with insufficient RBC production
- Trauma[30] or surgery, causing acute blood loss
- Gastrointestinal tract lesions,[30] causing either acute bleeds (e.g. variceal lesions, peptic ulcers, hemorrhoids[40]) or chronic blood loss (e.g. angiodysplasia)
- Gynecologic disturbances,[30] also generally causing chronic blood loss
- From menstruation, mostly among young women or older women who have fibroids
- Many type of cancers, including colorectal cancer and cancer of the urinary bladder, may cause acute or chronic blood loss, especially at advanced stages
- Infection by intestinal nematodes feeding on blood, such as hookworms[41] and the whipworm Trichuris trichiura [42]
- Iatrogenic anemia, blood loss from repeated blood draws and medical procedures.[43][44]
The roots of the words anemia and ischemia both refer to the basic idea of "lack of blood", but anemia and ischemia are not the same thing in modern medical terminology. The word anemia used alone implies widespread effects from blood that either is too scarce (e.g., blood loss) or is dysfunctional in its oxygen-supplying ability (due to whatever type of hemoglobin or erythrocyte problem). In contrast, the word ischemia refers solely to the lack of blood (poor perfusion). Thus ischemia in a body part can cause localized anemic effects within those tissues.[45]
Fluid overload
Fluid overload (hypervolemia) causes decreased hemoglobin concentration and apparent anemia:[46]
- General causes of hypervolemia include excessive sodium or fluid intake, sodium or water retention and fluid shift into the intravascular space.[47]
- From the 6th week of pregnancy, hormonal changes cause an increase in the mother's blood volume due to an increase in plasma.[48]
Intestinal inflammation
Certain gastrointestinal disorders can cause anemia. The mechanisms involved are multifactorial and not limited to malabsorption but mainly related to chronic intestinal inflammation, which causes dysregulation of hepcidin that leads to decreased access of iron to the circulation.[49][50][51]
- Helicobacter pylori infection.[52]
- Gluten-related disorders: untreated celiac disease[51][52] and non-celiac gluten sensitivity.[53] Anemia can be the only manifestation of celiac disease, in absence of gastrointestinal or any other symptoms.[54]
- Inflammatory bowel disease.[55][56]
Diagnosis

Definitions
There are a number of definitions of anemia; reviews provide comparison and contrast of them.[57] A strict but broad definition is an absolute decrease in red blood cell mass,[58] however, a broader definition is a lowered ability of the blood to carry oxygen.[59] An operational definition is a decrease in whole-blood hemoglobin concentration of more than 2 standard deviations below the mean of an age- and sex-matched reference range.[60]
It is difficult to directly measure RBC mass,[61] so the hematocrit (amount of RBCs) or the hemoglobin (Hb) in the blood are often used instead to indirectly estimate the value.[62] Hematocrit; however, is concentration dependent and is therefore not completely accurate. For example, during pregnancy a woman's RBC mass is normal but because of an increase in blood volume the hemoglobin and hematocrit are diluted and thus decreased. Another example would be bleeding where the RBC mass would decrease but the concentrations of hemoglobin and hematocrit initially remains normal until fluids shift from other areas of the body to the intravascular space.[citation needed]
The anemia is also classified by severity into mild (110 g/L to normal), moderate (80 g/L to 110 g/L), and severe anemia (less than 80 g/L) in adults.[63] Different values are used in pregnancy and children.[63]
Testing
Anemia is typically diagnosed on a complete blood count. Apart from reporting the number of red blood cells and the hemoglobin level, the automatic counters also measure the size of the red blood cells by flow cytometry, which is an important tool in distinguishing between the causes of anemia. Examination of a stained blood smear using a microscope can also be helpful, and it is sometimes a necessity in regions of the world where automated analysis is less accessible.[64]
| Age or gender group | Hb threshold (g/dL) | Hb threshold (mmol/L) |
|---|---|---|
| Children (0.5–5.0 yrs) | 11.0 | 6.8 |
| Children (5–12 yrs) | 11.5 | 7.1 |
| Teens (12–15 yrs) | 12.0 | 7.4 |
| Women, non-pregnant (>15yrs) | 12.0 | 7.4 |
| Women, pregnant | 11.0 | 6.8 |
| Men (>15yrs) | 13.0 | 8.1 |
A blood test will provide counts of white blood cells, red blood cells and platelets. If anemia appears, further tests may determine what type it is, and whether it has a serious cause. although of that, it is possible to refer to the genetic history and physical diagnosis.[66] These tests may include:
- complete blood count (CBC); a CBC is used to count the number of blood cells in a sample of the blood. For anemia, it will likely to be interested in the levels of the red blood cells contained in blood (hematocrit), hemoglobin, mean corpuscular volume.[67]
- determine the size and shape of red blood cells; some of red blood cells might also be examined for unusual size, shape and color.[68]
- serum ferritin; This protein helps store iron in the body, a low levels of ferritin usually indicates a low levels of stored iron.[68]
- serum vitamin B12; low levels usually develop an anemia, vitamin B12 is needed to make red blood cells, which carry oxygen to all parts of human body.[68]
- blood tests to detect rare causes; such as an immune attack on red blood cells, red blood cell fragility, and defects of enzymes, hemoglobin, and clotting.[67]
- a bone marrow sample; when the cause is unclear, a bone marrow test is performed, most often, when some blood cell defect is suspected.[67]
Reticulocyte counts, and the "kinetic" approach to anemia, have become more common than in the past in the large medical centers of the United States and some other wealthy nations, in part because some automatic counters now have the capacity to include reticulocyte counts. A reticulocyte count is a quantitative measure of the bone marrow's production of new red blood cells. The reticulocyte production index is a calculation of the ratio between the level of anemia and the extent to which the reticulocyte count has risen in response. If the degree of anemia is significant, even a "normal" reticulocyte count actually may reflect an inadequate response. If an automated count is not available, a reticulocyte count can be done manually following special staining of the blood film. In manual examination, activity of the bone marrow can also be gauged qualitatively by subtle changes in the numbers and the morphology of young RBCs by examination under a microscope. Newly formed RBCs are usually slightly larger than older RBCs and show polychromasia. Even where the source of blood loss is obvious, evaluation of erythropoiesis can help assess whether the bone marrow will be able to compensate for the loss and at what rate. When the cause is not obvious, clinicians use other tests, such as: ESR, serum iron, transferrin, RBC folate level, hemoglobin electrophoresis, renal function tests (e.g. serum creatinine) although the tests will depend on the clinical hypothesis that is being investigated. When the diagnosis remains difficult, a bone marrow examination allows direct examination of the precursors to red cells, although is rarely used as is painful, invasive and is hence reserved for cases where severe pathology needs to be determined or excluded.
Red blood cell size
In the morphological approach, anemia is classified by the size of red blood cells; this is either done automatically or on microscopic examination of a peripheral blood smear. The size is reflected in the mean corpuscular volume (MCV). If the cells are smaller than normal (under 80 fl), the anemia is said to be microcytic; if they are normal size (80–100 fl), normocytic; and if they are larger than normal (over 100 fl), the anemia is classified as macrocytic. This scheme quickly exposes some of the most common causes of anemia; for instance, a microcytic anemia is often the result of iron deficiency. In clinical workup, the MCV will be one of the first pieces of information available, so even among clinicians who consider the "kinetic" approach more useful philosophically, morphology will remain an important element of classification and diagnosis. Limitations of MCV include cases where the underlying cause is due to a combination of factors – such as iron deficiency (a cause of microcytosis) and vitamin B12 deficiency (a cause of macrocytosis) where the net result can be normocytic cells.
Production vs. destruction or loss
The "kinetic" approach to anemia yields arguably the most clinically relevant classification of anemia. This classification depends on evaluation of several hematological parameters, particularly the blood reticulocyte (precursor of mature RBCs) count. This then yields the classification of defects by decreased RBC production versus increased RBC destruction or loss. Clinical signs of loss or destruction include abnormal peripheral blood smear with signs of hemolysis; elevated LDH suggesting cell destruction; or clinical signs of bleeding, such as guaiac-positive stool, radiographic findings, or frank bleeding. The following is a simplified schematic of this approach:
| Anemia | |||||||||||||||||||||||||||||||||
| Reticulocyte production index shows inadequate production response to anemia. | Reticulocyte production index shows appropriate response to anemia = ongoing hemolysis or blood loss without RBC production problem. | ||||||||||||||||||||||||||||||||
| No clinical findings consistent with hemolysis or blood loss: pure disorder of production. | Clinical findings and abnormal MCV: hemolysis or loss and chronic disorder of production*. | Clinical findings and normal MCV= acute hemolysis or loss without adequate time for bone marrow production to compensate**. | |||||||||||||||||||||||||||||||
| Macrocytic anemia (MCV>100) | Normocytic anemia (80<MCV<100) | Microcytic anemia (MCV<80) | |||||||||||||||||||||||||||||||
* For instance, sickle cell anemia with superimposed iron deficiency; chronic gastric bleeding with B12 and folate deficiency; and other instances of anemia with more than one cause.
** Confirm by repeating reticulocyte count: ongoing combination of low reticulocyte production index, normal MCV and hemolysis or loss may be seen in bone marrow failure or anemia of chronic disease, with superimposed or related hemolysis or blood loss.
Here is a schematic representation of how to consider anemia with MCV as the starting point:
| Anemia | |||||||||||||||||||||||||||||||||||||||||||
| Macrocytic anemia (MCV>100) | Normocytic anemia (MCV 80–100) | Microcytic anemia (MCV<80) | |||||||||||||||||||||||||||||||||||||||||
| High reticulocyte count | Low reticulocyte count | ||||||||||||||||||||||||||||||||||||||||||
Other characteristics visible on the peripheral smear may provide valuable clues about a more specific diagnosis; for example, abnormal white blood cells may point to a cause in the bone marrow.
Microcytic
Microcytic anemia is primarily a result of hemoglobin synthesis failure/insufficiency, which could be caused by several etiologies:
Iron-deficiency anemia is the most common type of anemia overall and it has many causes. RBCs often appear hypochromic (paler than usual) and microcytic (smaller than usual) when viewed with a microscope.
- Iron-deficiency anemia is due to insufficient dietary intake or absorption of iron to meet the body's needs. Infants, toddlers, and pregnant women have higher than average needs. Increased iron intake is also needed to offset blood losses due to digestive tract issues, frequent blood donations, or heavy menstrual periods.[70] Iron is an essential part of hemoglobin, and low iron levels result in decreased incorporation of hemoglobin into red blood cells. In the United States, 12% of all women of childbearing age have iron deficiency, compared with only 2% of adult men. The incidence is as high as 20% among African American and Mexican American women.[71] In India it is even more than 50%.[72] Studies have linked iron deficiency without anemia to poor school performance and lower IQ in teenage girls, although this may be due to socioeconomic factors.[73][74] Iron deficiency is the most prevalent deficiency state on a worldwide basis. It is sometimes the cause of abnormal fissuring of the angular (corner) sections of the lips (angular stomatitis).
- In the United States, the most common cause of iron deficiency is bleeding or blood loss, usually from the gastrointestinal tract. Fecal occult blood testing, upper endoscopy and lower endoscopy should be performed to identify bleeding lesions. In older men and women, the chances are higher that bleeding from the gastrointestinal tract could be due to colon polyps or colorectal cancer.
- Worldwide, the most common cause of iron-deficiency anemia is parasitic infestation (hookworms, amebiasis, schistosomiasis and whipworms).[75]
The Mentzer index (mean cell volume divided by the RBC count) predicts whether microcytic anemia may be due to iron deficiency or thalassemia, although it requires confirmation.[76][citation needed]
Macrocytic
- Megaloblastic anemia, the most common cause of macrocytic anemia, is due to a deficiency of either vitamin B12, folic acid, or both.[77] Deficiency in folate or vitamin B12 can be due either to inadequate intake or insufficient absorption. Folate deficiency normally does not produce neurological symptoms, while B12 deficiency does.
- Pernicious anemia is caused by a lack of intrinsic factor, which is required to absorb vitamin B12 from food. A lack of intrinsic factor may arise from an autoimmune condition targeting the parietal cells (atrophic gastritis) that produce intrinsic factor or against intrinsic factor itself. These lead to poor absorption of vitamin B12.
- Macrocytic anemia can also be caused by the removal of the functional portion of the stomach, such as during gastric bypass surgery, leading to reduced vitamin B12/folate absorption. Therefore, one must always be aware of anemia following this procedure.
- Hypothyroidism
- Alcoholism commonly causes a macrocytosis, although not specifically anemia. Other types of liver disease can also cause macrocytosis.
- Drugs such as methotrexate, zidovudine, and other substances may inhibit DNA replication such as heavy metals
Macrocytic anemia can be further divided into "megaloblastic anemia" or "nonmegaloblastic macrocytic anemia". The cause of megaloblastic anemia is primarily a failure of DNA synthesis with preserved RNA synthesis, which results in restricted cell division of the progenitor cells. The megaloblastic anemias often present with neutrophil hypersegmentation (six to 10 lobes). The nonmegaloblastic macrocytic anemias have different etiologies (i.e. unimpaired DNA globin synthesis,) which occur, for example, in alcoholism. In addition to the nonspecific symptoms of anemia, specific features of vitamin B12 deficiency include peripheral neuropathy and subacute combined degeneration of the cord with resulting balance difficulties from posterior column spinal cord pathology.[78] Other features may include a smooth, red tongue and glossitis. The treatment for vitamin B12-deficient anemia was first devised by William Murphy, who bled dogs to make them anemic, and then fed them various substances to see what (if anything) would make them healthy again. He discovered that ingesting large amounts of liver seemed to cure the disease. George Minot and George Whipple then set about to isolate the curative substance chemically and ultimately were able to isolate the vitamin B12 from the liver. All three shared the 1934 Nobel Prize in Medicine.[79]
Normocytic
Normocytic anemia occurs when the overall hemoglobin levels are decreased, but the red blood cell size (mean corpuscular volume) remains normal. Causes include:
Dimorphic
A dimorphic appearance on a peripheral blood smear occurs when there are two simultaneous populations of red blood cells, typically of different size and hemoglobin content (this last feature affecting the color of the red blood cell on a stained peripheral blood smear). For example, a person recently transfused for iron deficiency would have small, pale, iron deficient red blood cells (RBCs) and the donor RBCs of normal size and color. Similarly, a person transfused for severe folate or vitamin B12 deficiency would have two cell populations, but, in this case, the patient's RBCs would be larger and paler than the donor's RBCs. A person with sideroblastic anemia (a defect in heme synthesis, commonly caused by alcoholism, but also drugs/toxins, nutritional deficiencies, a few acquired and rare congenital diseases) can have a dimorphic smear from the sideroblastic anemia alone. Evidence for multiple causes appears with an elevated RBC distribution width (RDW), indicating a wider-than-normal range of red cell sizes, also seen in common nutritional anemia.[citation needed]
Heinz body anemia
Heinz bodies form in the cytoplasm of RBCs and appear as small dark dots under the microscope. In animals, Heinz body anemia has many causes. It may be drug-induced, for example in cats and dogs by acetaminophen (paracetamol),[80] or may be caused by eating various plants or other substances:
- In cats and dogs after eating either raw or cooked plants from the genus Allium, for example, onions or garlic.[81]
- In dogs after ingestion of zinc, for example, after eating U.S. pennies minted after 1982.[80]
- In horses which eat dry or wilted red maple leaves.[82]
Hyperanemia
Hyperanemia is a severe form of anemia, in which the hematocrit is below 10%.[83]
Refractory anemia
Refractory anemia, an anemia which does not respond to treatment,[84] is often seen secondary to myelodysplastic syndromes.[85] Iron-deficiency anemia may also be refractory as a manifestation of gastrointestinal problems which disrupt iron absorption or cause occult bleeding. [86]
Transfusion dependent
Transfusion dependent anemia is a form of anemia where ongoing blood transfusion are required.[87] Most people with myelodysplastic syndrome develop this state at some point in time.[88] Beta thalassemia may also result in transfusion dependence.[89][90] Concerns from repeated blood transfusions include iron overload.[88] This iron overload may require chelation therapy.[91]
Treatment
The global market for anemia treatments is estimated at more than USD 23 billion per year and is fast growing because of the rising prevalence and awareness of anemia. The types of anemia treated with drugs are iron-deficiency anemia, thalassemia, aplastic anemia, hemolytic anemia, sickle cell anemia, and pernicious anemia, the most important of them being deficiency and sickle cell anemia with together 60% of market share because of highest prevalence as well as higher treatment costs compared with other types.[14] Treatment for anemia depends on cause and severity. Vitamin supplements given orally (folic acid or vitamin B12) or intramuscularly (vitamin B12) will replace specific deficiencies.[1] Apart from that iron supplements, antibiotics, immunosuppressant, bone marrow stimulants, corticosteroids, gene therapy and iron chelating agents are forms of anemia treatment drugs, with immunosuppressants and corticosteroids accounting for 58% of the market share. A paradigm shift towards gene therapy and monoclonal antibody therapies are observed.[14]
Oral iron
Nutritional iron deficiency is common in developing nations. An estimated two-thirds of children and of women of childbearing age in most developing nations are estimated to have iron deficiency without anemia; one-third of them have iron deficiency with anemia.[92] Iron deficiency due to inadequate dietary iron intake is rare in men and postmenopausal women. The diagnosis of iron deficiency mandates a search for potential sources of blood loss, such as gastrointestinal bleeding from ulcers or colon cancer.[citation needed]
Mild to moderate iron-deficiency anemia is treated by oral iron supplementation with ferrous sulfate, ferrous fumarate, or ferrous gluconate. Daily iron supplements have been shown to be effective in reducing anemia in women of childbearing age.[93] When taking iron supplements, stomach upset or darkening of the feces are commonly experienced. The stomach upset can be alleviated by taking the iron with food; however, this decreases the amount of iron absorbed. Vitamin C aids in the body's ability to absorb iron, so taking oral iron supplements with orange juice is of benefit.[94]
In the anemia of chronic kidney disease, recombinant erythropoietin or epoetin alfa is recommended to stimulate RBC production, and if iron deficiency and inflammation are also present, concurrent parenteral iron is also recommended.[95]
Injectable iron
In cases where oral iron has either proven ineffective, would be too slow (for example, pre-operatively), or where absorption is impeded (for example in cases of inflammation), parenteral iron preparations can be used. Parenteral iron can improve iron stores rapidly and is also effective for treating people with postpartum haemorrhage, inflammatory bowel disease, and chronic heart failure.[6] The body can absorb up to 6 mg iron daily from the gastrointestinal tract. In many cases, the patient has a deficit of over 1,000 mg of iron which would require several months to replace. This can be given concurrently with erythropoietin to ensure sufficient iron for increased rates of erythropoiesis.[96]
Blood transfusions
Blood transfusions in those without symptoms is not recommended until the hemoglobin is below 60 to 80 g/L (6 to 8 g/dL).[1] In those with coronary artery disease who are not actively bleeding transfusions are only recommended when the hemoglobin is below 70 to 80g/L (7 to 8 g/dL).[12] Transfusing earlier does not improve survival.[97] Transfusions otherwise should only be undertaken in cases of cardiovascular instability.[98]
A 2012 review concluded that when considering blood transfusions for anaemia in people with advanced cancer who have fatigue and breathlessness (not related to cancer treatment or haemorrhage), consideration should be given to whether there are alternative strategies can be tried before a blood transfusion.[99]
Vitamin B12 intramuscular injections
In many cases, vitamin B12 is used by intramuscular injection in severe cases or cases of malabsorption of dietary-B12. Pernicious anemia caused by loss of intrinsic factor cannot be prevented.[100] If there are other, reversible causes of low vitamin B12 levels, the cause must be treated.[101]
Vitamin B12 deficiency anemia is usually easily treated by providing the necessary level of vitamin B12 supplementation.[102] The injections are quick-acting, and symptoms usually go away within one to two weeks.[102] As the condition improves, doses are reduced to weeks and then can be given monthly. Intramuscular therapy leads to more rapid improvement and should be considered in patients with severe deficiency or severe neurologic symptoms.[102] Treatment should begin rapidly for severe neurological symptoms, as some changes can become permanent.[103] In some individuals lifelong treatment may be needed.[103]
Erythropoiesis-stimulating agents
The objective for the administration of an erythropoiesis-stimulating agent (ESA) is to maintain hemoglobin at the lowest level that both minimizes transfusions and meets the individual person's needs.[104] They should not be used for mild or moderate anemia.[97] They are not recommended in people with chronic kidney disease unless hemoglobin levels are less than 10 g/dL or they have symptoms of anemia. Their use should be along with parenteral iron.[104][105] The 2020 Cochrane Anaesthesia Review Group review of erythropoietin (EPO) plus iron versus control treatment including placebo or iron for preoperative anaemic adults undergoing non‐cardiac surgery [106] demonstrated that patients were much less likely to require red cell transfusion and in those transfused, the volumes were unchanged (mean difference -0.09, 95% CI -0.23 to 0.05). Pre-operative hemoglobin concentration was increased in those receiving 'high dose' EPO, but not 'low dose'.[citation needed]
Hyperbaric oxygen
Treatment of exceptional blood loss (anemia) is recognized as an indication for hyperbaric oxygen (HBO) by the Undersea and Hyperbaric Medical Society.[107][108] The use of HBO is indicated when oxygen delivery to tissue is not sufficient in patients who cannot be given blood transfusions for medical or religious reasons. HBO may be used for medical reasons when threat of blood product incompatibility or concern for transmissible disease are factors.[107] The beliefs of some religions (ex: Jehovah's Witnesses) may require they use the HBO method.[107] A 2005 review of the use of HBO in severe anemia found all publications reported positive results.[109]
Preoperative anemia
An estimated 30% of adults who require non-cardiac surgery have anemia.[110] In order to determine an appropriate preoperative treatment, it is suggested that the cause of anemia be first determined.[111] There is moderate level medical evidence that supports a combination of iron supplementation and erythropoietin treatment to help reduce the requirement for red blood cell transfusions after surgery in those who have preoperative anemia.[110]
Epidemiology
Anemia affects 27% of the world's population with iron-deficiency anemia accounting for more than 60% of it.[112] A moderate degree of iron-deficiency anemia affected approximately 610 million people worldwide or 8.8% of the population.[15] It is somewhat more common in females (9.9%) than males (7.8%).[15] Mild iron-deficiency anemia affects another 375 million.[15] Severe anaemia is prevalent globally, and especially in sub-Saharan Africa[113] where it is associated with infections including malaria and invasive bacterial infections.[114]
History
Signs of severe anemia in human bones from 4000 years ago have been uncovered in Thailand.[115]
References
- ↑ 1.00 1.01 1.02 1.03 1.04 1.05 1.06 1.07 1.08 1.09 1.10 1.11 1.12 1.13 1.14 1.15 1.16 1.17 1.18 1.19 1.20 1.21 1.22 1.23 1.24 "Anemia in the emergency department: evaluation and treatment". Emergency Medicine Practice 15 (11): 1–15; quiz 15–16. November 2013. PMID 24716235. http://www.ebmedicine.net/topics.php?paction=showTopic&topic_id=385.
- ↑ 2.0 2.1 Vos, Theo et al. (October 2016). "Global, regional, and national incidence, prevalence, and years lived with disability for 310 diseases and injuries, 1990–2015: a systematic analysis for the Global Burden of Disease Study 2015". Lancet 388 (10053): 1545–1602. doi:10.1016/S0140-6736(16)31678-6. PMID 27733282.
- ↑ "Anemia: Practice Essentials, Pathophysiology, Etiology". 9 November 2021. https://emedicine.medscape.com/article/198475-overview.
- ↑ 4.0 4.1 4.2 "Anemia | NHLBI, NIH". https://www.nhlbi.nih.gov/health-topics/anemia.
- ↑ "anaemia". http://dictionary.reference.com/browse/anaemia.
- ↑ 6.0 6.1 Ng, Oliver; Keeler, Barrie D; Mishra, Amitabh; Simpson, J A; Neal, Keith; Al-Hassi, Hafid Omar; Brookes, Matthew J; Acheson, Austin G (7 December 2019). "Iron therapy for preoperative anaemia". Cochrane Database of Systematic Reviews 2019 (12): CD011588. doi:10.1002/14651858.CD011588.pub3. PMID 31811820.
- ↑ "Anemia - Symptoms and causes" (in en). https://www.mayoclinic.org/diseases-conditions/anemia/symptoms-causes/syc-20351360.
- ↑ "The clinical and economic burden of anemia". The American Journal of Managed Care 16 Suppl Issues: S59–66. March 2010. PMID 20297873.
- ↑ Rhodes, Carl E.; Varacallo, Matthew (2019-03-04). Physiology, Oxygen Transport. PMID 30855920. https://www.ncbi.nlm.nih.gov/books/NBK538336/. Retrieved 2019-05-04.
- ↑ Payne, Michael W.C.; Uhthoff, Hans K.; Trudel, Guy (January 2007). "Anemia of immobility: Caused by adipocyte accumulation in bone marrow". Medical Hypotheses 69 (4): 778–786. doi:10.1016/j.mehy.2007.01.077. PMID 17408874.
- ↑ "Evidence-based interventions for improvement of maternal and child nutrition: what can be done and at what cost?". Lancet 382 (9890): 452–477. August 2013. doi:10.1016/S0140-6736(13)60996-4. PMID 23746776.
- ↑ 12.0 12.1 12.2 "Treatment of anemia in patients with heart disease: a clinical practice guideline from the American College of Physicians". Annals of Internal Medicine 159 (11): 770–779. December 2013. doi:10.7326/0003-4819-159-11-201312030-00009. PMID 24297193.
- ↑ Peyrin-Biroulet, Laurent; Williet, Nicolas; Cacoub, Patrice (1 December 2015). "Guidelines on the diagnosis and treatment of iron deficiency across indications: a systematic review". The American Journal of Clinical Nutrition 102 (6): 1585–1594. doi:10.3945/ajcn.114.103366. PMID 26561626.
- ↑ 14.0 14.1 14.2 "Anemia Treatment Drugs: 2019 Global Market Study; Analyzed by Type of Anemia, Type of Drug, and Geography". GlobeNewswire (Press release). 2019-04-26. Retrieved 2023-08-02.
- ↑ 15.0 15.1 15.2 15.3 15.4 "Years lived with disability (YLDs) for 1160 sequelae of 289 diseases and injuries 1990-2010: a systematic analysis for the Global Burden of Disease Study 2010". Lancet 380 (9859): 2163–2196. December 2012. doi:10.1016/S0140-6736(12)61729-2. PMID 23245607. PMC 6350784. http://www.documentation.ird.fr/hor/fdi:010059240.
- ↑ ((GBD 2013 Mortality Causes of Death Collaborators)) (January 2015). "Global, regional, and national age-sex specific all-cause and cause-specific mortality for 240 causes of death, 1990-2013: a systematic analysis for the Global Burden of Disease Study 2013". Lancet 385 (9963): 117–71. doi:10.1016/S0140-6736(14)61682-2. PMID 25530442.
- ↑ "WHO Global Anaemia estimates, 2021 Edition". Wolrd Health Organization. https://www.who.int/data/gho/data/themes/topics/anaemia_in_women_and_children.
- ↑ "WHO | Interventions by global target". World Health Organization. https://www.who.int/elena/global-targets/en/.
- ↑ "The case for action on anemia". Devex. 14 June 2016. https://www.devex.com/news/sponsored/the-case-for-action-on-anemia-leave-no-one-behind-88283.
- ↑ 20.0 20.1 eMedicineHealth > anemia article Author: Saimak T. Nabili, MD, MPH. Editor: Melissa Conrad Stöppler, MD. Last Editorial Review: 12/9/2008. Retrieved on 4 April 2009
- ↑ "Exercising With Anemia: Prescription for Health" (in en). http://www.medscape.com/viewarticle/719391.
- ↑ Weckmann, Gesine; Kiel, Simone; Chenot, Jean-François; Angelow, Aniela (2023-01-24). "Association of Anemia with Clinical Symptoms Commonly Attributed to Anemia - Analysis of Two Population-Based Cohorts" (in English). Journal of Clinical Medicine 12 (3): 921. doi:10.3390/jcm12030921. ISSN 2077-0383. PMID 36769569.
- ↑ 23.0 23.1 23.2 23.3 "What Are Symptoms of Anemia?". 2022-03-24. https://www.nhlbi.nih.gov/health/anemia/symptoms.
- ↑ "Anemia" (in en). https://www.hematology.org:443/education/patients/anemia.
- ↑ Franceschi, Lucia De; Iolascon, Achille; Taher, Ali; Cappellini, Maria Domenica (2017-07-01). "Clinical management of iron deficiency anemia in adults: Systemic review on advances in diagnosis and treatment" (in English). European Journal of Internal Medicine 42: 16–23. doi:10.1016/j.ejim.2017.04.018. ISSN 0953-6205. PMID 28528999. https://www.ejinme.com/article/S0953-6205(17)30165-6/abstract.
- ↑ Weksler, Babette (2017) (in en). Wintrobe's Atlas of Clinical Hematology. Lippincott Williams & Wilkins. p. PT105. ISBN 9781451154542. https://books.google.com/books?id=FTwtDwAAQBAJ&pg=PT105.
- ↑ "Mental Health and Pica" (in en). https://www.webmd.com/mental-health/mental-health-pica.
- ↑ Allen, Richard P.; Auerbach, Sarah; Bahrain, Huzefa; Auerbach, Michael; Earley, Christopher J. (April 2013). "The prevalence and impact of restless legs syndrome on patients with iron deficiency anemia". American Journal of Hematology 88 (4): 261–264. doi:10.1002/ajh.23397. PMID 23494945.
- ↑ "Sickle Cell Disease". 22 July 2022. https://www.nhlbi.nih.gov/health-topics/sickle-cell-disease.
- ↑ 30.00 30.01 30.02 30.03 30.04 30.05 30.06 30.07 30.08 30.09 30.10 30.11 30.12 30.13 30.14 30.15 30.16 30.17 30.18 30.19 30.20 30.21 30.22 30.23 30.24 30.25 30.26 Table 12-1 in: Mitchell, Richard Sheppard; Kumar, Vinay; Abbas, Abul K.; Fausto, Nelson (2007). Robbins Basic Pathology (8th ed.). Philadelphia: Saunders. ISBN 978-1-4160-2973-1.
- ↑ Gregg, XT; Prchal, JT (2007). "Anemia of Endocrine Disorders". Williams Hermatology. McGraw-Hill.
- ↑ "the definition of leukoerythroblastosis" (in en). https://www.dictionary.com/browse/leukoerythroblastosis.
- ↑ Despotovic, J; Mahoney, D; Armsby, C (2021). "Overview of hemolytic anemias in children". UpToDate. https://www.lecturio.com/concepts/anemia-overview/.
- ↑ Capriotti, Theresa (2016). Pathophysiology : introductory concepts and clinical perspectives. Frizzell, Joan Parker. Philadelphia. ISBN 978-0-8036-1571-7. OCLC 900626405.
- ↑ Mitchell, Richard Sheppard; Kumar, Vinay; Abbas, Abul K.; Fausto, Nelson (2007). Robbins Basic Pathology (8th ed.). Philadelphia: Saunders. p. 432. ISBN 978-1-4160-2973-1.
- ↑ Cotran, Ramzi S.; Kumar, Vinay; Fausto, Nelson; Robbins, Stanley L.; Abbas, Abul K. (2005). Robbins and Cotran pathologic basis of disease. St. Louis, Mo: Elsevier Saunders. p. 637. ISBN 978-0-7216-0187-8.
- ↑ "Autoimmune Hemolytic Anemia (AIHA)" By J.L. Jenkins. The Regional Cancer Center. 2001
- ↑ "Primary chronic cold agglutinin disease: an update on pathogenesis, clinical features and therapy". Hematology 12 (5): 361–370. October 2007. doi:10.1080/10245330701445392. PMID 17891600.
- ↑ Stijlemans, Benoît; Guilliams, Martin; Raes, Geert; Beschin, Alain; Magez, Stefan; De Baetselier, Patrick (2007). "African trypanosomosis: From immune escape and immunopathology to immune intervention". Veterinary Parasitology (American Association of Veterinary Parasitologists (AAVP) + European Veterinary Parasitology College (EVPC) + World Association for the Advancement of Veterinary Parasitology (WAAVP) (Elsevier)) 148 (1): 3–13. doi:10.1016/j.vetpar.2007.05.005. ISSN 0304-4017. PMID 17560035.
- ↑ "Do Hemorrhoids Cause Iron Deficiency Anemia?". 26 June 2018. https://lacolon.com/article/hemorrhoids-iron-deficiency-can-hemorrhoids-cause-iron-deficiency-anemia.
- ↑ "Hookworm-related anaemia among pregnant women: a systematic review". PLOS Neglected Tropical Diseases 2 (9): e291. September 2008. doi:10.1371/journal.pntd.0000291. PMID 18820740.
- ↑ "Trichuris and hookworm infections associated with anaemia during pregnancy". Tropical Medicine & International Health 16 (4): 531–537. April 2011. doi:10.1111/j.1365-3156.2011.02727.x. PMID 21281406.
- ↑ Whitehead, Nedra S.; Williams, Laurina O.; Meleth, Sreelatha; Kennedy, Sara M.; Ubaka-Blackmoore, Nneka; Geaghan, Sharon M.; Nichols, James H.; Carroll, Patrick et al. (December 2019). "Interventions to prevent iatrogenic anemia: a Laboratory Medicine Best Practices systematic review". Critical Care 23 (1): 278. doi:10.1186/s13054-019-2511-9. PMID 31399052.
- ↑ Martin, Niels D.; Scantling, Dane (September 2015). "Hospital-Acquired Anemia: A Contemporary Review of Etiologies and Prevention Strategies". Journal of Infusion Nursing 38 (5): 330–338. doi:10.1097/NAN.0000000000000121. PMID 26339939.
- ↑ Bellotto, Fabio; Cati, Arianna (March 2006). "[Anemia and myocardial ischemia: relationships and interferences"]. Recenti Progressi in Medicina 97 (3): 153–164. ISSN 0034-1193. PMID 16700423. https://pubmed.ncbi.nlm.nih.gov/16700423/.
- ↑ Hung, Szu-Chun; Kuo, Ko-Lin; Peng, Ching-Hsiu; Wu, Che-Hsiung; Wang, Yi-Chun; Tarng, Der-Cherng (2015). "Association of Fluid Retention With Anemia and Clinical Outcomes Among Patients With Chronic Kidney Disease". Journal of the American Heart Association 4 (1): e001480. doi:10.1161/JAHA.114.001480. PMID 25559015.
- ↑ "Fluid imbalances". Portable Fluids and Electrolytes (Portable Series). Hagerstwon, MD: Lippincott Williams & Wilkins. 2007. p. 62. ISBN 978-1-58255-678-9.
- ↑ "ISBT: 8. Obstetric anaemia" (in en). http://www.isbtweb.org/working-parties/clinical-transfusion/8-obstetric-anaemia/.
- ↑ "Iron and inflammation - the gut reaction". Metallomics 9 (2): 101–111. February 2017. doi:10.1039/c6mt00282j. PMID 28067386.
- ↑ "Anemia in inflammatory bowel disease: a neglected issue with relevant effects". World Journal of Gastroenterology 20 (13): 3542–3551. April 2014. doi:10.3748/wjg.v20.i13.3542. PMID 24707137.
- ↑ 51.0 51.1 Leffler, Daniel A.; Green, Peter H. R.; Fasano, Alessio (October 2015). "Extraintestinal manifestations of coeliac disease". Nature Reviews Gastroenterology & Hepatology 12 (10): 561–571. doi:10.1038/nrgastro.2015.131. PMID 26260366.
- ↑ 52.0 52.1 "Anemia and iron deficiency in gastrointestinal and liver conditions". World Journal of Gastroenterology 22 (35): 7908–7925. September 2016. doi:10.3748/wjg.v22.i35.7908. PMID 27672287.
- ↑ "Non-Celiac Gluten sensitivity: the new frontier of gluten related disorders". Nutrients 5 (10): 3839–3853. September 2013. doi:10.3390/nu5103839. PMID 24077239.
- ↑ James, Stephen P. (April 2005). "National Institutes of Health Consensus Development Conference statement on Celiac Disease, June 28–30, 2004". Gastroenterology 128 (4): S1–S9. doi:10.1053/j.gastro.2005.02.007. PMID 15825115.
- ↑ "Dietary and nutritional considerations for inflammatory bowel disease". The Proceedings of the Nutrition Society 70 (3): 329–335. August 2011. doi:10.1017/S0029665111000097. PMID 21450124.
- ↑ "The aetiology and impact of malnutrition in paediatric inflammatory bowel disease". Journal of Human Nutrition and Dietetics 24 (4): 313–326. August 2011. doi:10.1111/j.1365-277X.2011.01171.x. PMID 21564345.
- ↑ "The definition of anemia: what is the lower limit of normal of the blood hemoglobin concentration?". Blood 107 (5): 1747–1750. March 2006. doi:10.1182/blood-2005-07-3046. PMID 16189263.
- ↑ Anemia at eMedicine
- ↑ Rodak, Bernadette F. (2007). Hematology: Clinical Principles and Applications (3rd ed.). Philadelphia: Saunders. p. 220. ISBN 978-1-4160-3006-5. https://books.google.com/books?id=6sfacydDNsUC&pg=PA220.
- ↑ Pomeranz, Albert J.; Sabnis, Svapna; Busey, Sharon; Kliegman, Robert M. (2016). Pediatric Decision-Making Strategies (2nd ed.). Elsevier. ISBN 978-0-323-29854-4.
- ↑ Polin, Richard A.; Abman, Steven H.; Rowitch, David; Benitz, William E. (2016). Fetal and Neonatal Physiology (5 ed.). Elsevier Health Sciences. p. 1085. ISBN 978-0-323-35232-1. https://books.google.com/books?id=JootDAAAQBAJ&pg=PA1085.
- ↑ Uthman, Ed (2009). Understanding Anemia. Univ. Press of Mississippi. p. 23. ISBN 978-1-60473-701-1. https://books.google.com/books?id=2yBl75DJ8_kC&pg=PA23.
- ↑ 63.0 63.1 Organization, World Health (2011). Haemoglobin concentrations for the diagnosis of anaemia and assessment of severity. World Health Organization.
- ↑ Sacirović, Selim; Asotic; Maksimovic; Radevic; Muric; Mekic; Biocanin (2013). "Monitoring and Prevention of Anemia Relying on Nutrition and Environmental Conditions in Sports". https://www.ncbi.nlm.nih.gov/pmc/articles/PMC3769080/.
- ↑ World Health Organization (2008). Worldwide prevalence of anaemia 1993–2005. Geneva: World Health Organization. ISBN 978-92-4-159665-7. http://whqlibdoc.who.int/publications/2008/9789241596657_eng.pdf. Retrieved 2009-03-25.
- ↑ "Anemia" (in en). https://www.radiologyinfo.org/en/info/anemia.
- ↑ 67.0 67.1 67.2 "How Anemia Is Diagnosed and Treated" (in en). https://www.webmd.com/a-to-z-guides/understanding-anemia-treatment.
- ↑ 68.0 68.1 68.2 "Anemia Types, Treatment, Symptoms, Signs, Causes & Iron Deficiency" (in en). https://www.emedicinehealth.com/anemia/article_em.htm.
- ↑ Caito, Samuel; Almeida Lopes, Ana Carolina B.; Paoliello, Monica M. B.; Aschner, Michael (2017). "Chapter 16. Toxicology of Lead and Its Damage to Mammalian Organs". in Astrid, S.; Helmut, S.; Sigel, R. K. O.. Lead: Its Effects on Environment and Health. Metal Ions in Life Sciences. 17. de Gruyter. pp. 501–534. doi:10.1515/9783110434330-016. ISBN 9783110434330.
- ↑ Recommendations to Prevent and Control Iron Deficiency in the United States MMWR 1998;47 (No. RR-3) p. 5
- ↑ Centers for Disease Control Prevention (CDC) (October 11, 2002). "Iron Deficiency – United States, 1999–2000". MMWR 51 (40): 897–899. PMID 12418542. https://www.cdc.gov/mmwr/preview/mmwrhtml/mm5140a1.htm. Retrieved 21 April 2012.
- ↑ "Global Iron-Deficiency Anemia Therapy Market – Industry Trends and Forecast to 2027 -". https://www.databridgemarketresearch.com/reports/global-iron-deficiency-anemia-therapy-market.
- ↑ "Iron deficiency and cognitive achievement among school-aged children and adolescents in the United States". Pediatrics 107 (6): 1381–1386. June 2001. doi:10.1542/peds.107.6.1381. PMID 11389261.
- ↑ "A review of studies on the effect of iron deficiency on cognitive development in children". The Journal of Nutrition 131 (2S–2): 649S–666S; discussion 666S–668S. February 2001. doi:10.1093/jn/131.2.649S. PMID 11160596.
- ↑ "Iron Deficiency Anaemia: Assessment, Prevention, and Control: A guide for programme managers". https://www.who.int/nutrition/publications/en/ida_assessment_prevention_control.pdf.
- ↑ "Differentiation of iron deficiency from thalassaemia trait". Lancet 1 (7808): 882. April 1973. doi:10.1016/s0140-6736(73)91446-3. PMID 4123424.
- ↑ "Macrocytic Anemia - an overview". https://www.sciencedirect.com/topics/medicine-and-dentistry/macrocytic-anemia.
- ↑ eMedicine – "Vitamin B-12 Associated Neurological Diseases": Article by Niranjan N Singh, July 18, 2006. .
- ↑ "Physiology or Medicine 1934 – Presentation Speech". Nobelprize.org. 1934-12-10. http://nobelprize.org/nobel_prizes/medicine/laureates/1934/press.html.
- ↑ 80.0 80.1 Harvey, John W. (2012). Veterinary hematology: a diagnostic guide and color atlas. St. Louis, MO: Elsevier/Saunders. p. 104. ISBN 978-1-4377-0173-9.
- ↑ Hovda, L; Brutlag, A; Poppenga, RH et al., eds (2016). "Chapter 69: Onions and garlic". Blackwell's Five-Minute Veterinary Consult Clinical Companion: Small Animal Toxicology (2nd ed.). John Wiley & Sons. pp. 515–520. ISBN 978-1-119-03652-4.
- ↑ Peek, SF (2014). "Chapter 117: Hemolytic disorders". in Sprayberry, KA; Robinson, NE. Robinson's Current Therapy in Equine Medicine (7th ed.). Elsevier Health Sciences. pp. 492–496. ISBN 978-0-323-24216-5.
- ↑ "Laboratory evaluation of anemia". The Western Journal of Medicine 146 (4): 443–451. April 1987. PMID 3577135.
- ↑ "MedTerms Definition: Refractory Anemia". Medterms.com. 2011-04-27. http://www.medterms.com/script/main/art.asp?articlekey=5275.
- ↑ "Good Source for later". Atlasgeneticsoncology.org. http://atlasgeneticsoncology.org/Anomalies/RAID1104.html.
- ↑ "Refractory iron deficiency anemia as the primary clinical manifestation of celiac disease". Journal of Pediatric Hematology/Oncology 25 (2): 169–172. February 2003. doi:10.1097/00043426-200302000-00018. PMID 12571473.
- ↑ "What are RBC-transfusion-dependence and -independence?". Leukemia Research 35 (1): 8–11. January 2011. doi:10.1016/j.leukres.2010.07.015. PMID 20692036.
- ↑ 88.0 88.1 "Management of RBC-transfusion dependence". Hematology. American Society of Hematology. Education Program 2007: 398–404. 2007. doi:10.1182/asheducation-2007.1.398. PMID 18024657.
- ↑ Hillyer, Christopher D.; Silberstein, Leslie E.; Ness, Paul M.; Anderson, Kenneth C.; Roback, John D. (2006). Blood Banking and Transfusion Medicine: Basic Principles and Practice. Elsevier Health Sciences. p. 534. ISBN 9780702036255. https://books.google.com/books?id=8iEPDQAAQBAJ&pg=PT556.
- ↑ Mandel, Jess; Taichman, Darren (2006) (in en). Pulmonary Vascular Disease. Elsevier Health Sciences. p. 170. ISBN 978-1416022466. https://books.google.com/books?id=v-pr4P34QjIC&pg=PA170.
- ↑ Ferri, Fred F. (2015) (in en). BOPOD – Ferri's Clinical Advisor 2016. Elsevier Health Sciences. p. 1131.e2. ISBN 978-0323378222. https://books.google.com/books?id=bbLSCQAAQBAJ&pg=PA1131-IA2.
- ↑ "Strategies to control nutritional anemia". The American Journal of Clinical Nutrition 64 (5): 789–790. November 1996. doi:10.1093/ajcn/64.5.789. PMID 8901803.
- ↑ Low, MS; Speedy, J; Styles, CE; De-Regil, LM; Pasricha, SR (18 April 2016). "Daily iron supplementation for improving anaemia, iron status and health in menstruating women.". The Cochrane Database of Systematic Reviews 2016 (4): CD009747. doi:10.1002/14651858.CD009747.pub2. PMID 27087396.
- ↑ "Intravenous ascorbic acid administration for erythropoietin-hyporesponsive anemia in iron loaded hemodialysis patients". Artificial Organs 26 (4): 366–370. April 2002. doi:10.1046/j.1525-1594.2002.06888.x. PMID 11952508.
- ↑ "Anaemia management in people with chronic kidney disease | Guidance and guidelines | NICE". 9 February 2011. http://guidance.nice.org.uk/CG114/Guidance/pdf/English.
- ↑ "Clinical use of intravenous iron: administration, efficacy, and safety". Hematology. American Society of Hematology. Education Program 2010: 338–347. 2010. doi:10.1182/asheducation-2010.1.338. PMID 21239816.
- ↑ 97.0 97.1 "Treatment of anemia in patients with heart disease: a systematic review". Annals of Internal Medicine 159 (11): 746–757. December 2013. doi:10.7326/0003-4819-159-11-201312030-00007. PMID 24297191.
- ↑ . British Society of Gastroenterology"Guidelines for the management of iron deficiency anaemia". Gut 60 (10): 1309–1316. October 2011. doi:10.1136/gut.2010.228874. PMID 21561874.
- ↑ Preston, Nancy J; Hurlow, Adam; Brine, Jennifer; Bennett, Michael I (15 February 2012). "Blood transfusions for anaemia in patients with advanced cancer". Cochrane Database of Systematic Reviews 2012 (2): CD009007. doi:10.1002/14651858.CD009007.pub2. PMID 22336857.
- ↑ "Pernicious anemia: MedlinePlus Medical Encyclopedia" (in en). https://medlineplus.gov/ency/article/000569.htm.
- ↑ Hankey, Graeme J. (2008). Clinical neurology. Joanna M. Wardlaw. London: Manson. ISBN 978-1-84076-518-2. OCLC 503441695. https://www.worldcat.org/oclc/503441695.
- ↑ 102.0 102.1 102.2 Langan, Robert C.; Goodbred, Andrew J. (2017-09-15). "Vitamin B12 Deficiency: Recognition and Management" (in en-US). American Family Physician 96 (6): 384–389. PMID 28925645. https://www.aafp.org/pubs/afp/issues/2017/0915/p384.html.
- ↑ 103.0 103.1 "Pernicious Anemia Clinical Presentation: History, Physical Examination". 2017-09-14. http://emedicine.medscape.com/article/204930-clinical#b3.
- ↑ 104.0 104.1 "September 2007 update on EORTC guidelines and anemia management with erythropoiesis-stimulating agents". The Oncologist 13 Suppl 3 (Supplement 3): 33–36. 2008. doi:10.1634/theoncologist.13-S3-33. PMID 18458123.
- ↑ American Society of Nephrology, "Five Things Physicians and Patients Should Question", Choosing Wisely: an initiative of the ABIM Foundation (American Society of Nephrology), http://choosingwisely.org/wp-content/uploads/2012/04/5things_12_factsheet_Amer_Soc_Neph.pdf, retrieved August 17, 2012
- ↑ "Erythropoietin plus iron versus control treatment including placebo or iron for preoperative anaemic adults undergoing non-cardiac surgery". Cochrane Database of Systematic Reviews 2020 (8): CD012451. 2020. doi:10.1002/14651858.CD012451.pub2. PMID 32790892.
- ↑ 107.0 107.1 107.2 "Exceptional Blood Loss – Anemia". http://www.uhms.org/ResourceLibrary/Indications/ExceptionalBloodLossAnemia/tabid/277/Default.aspx.
- ↑ "Hyperbaric oxygen in exceptional acute blood-loss anemia". J. Hyperbaric Med 2 (4): 205–210. 1987. http://archive.rubicon-foundation.org/4352. Retrieved 2008-05-19.
- ↑ "A systematic review of the application of hyperbaric oxygen in the treatment of severe anemia: an evidence-based approach". Undersea & Hyperbaric Medicine 32 (1): 61–83. 2005. PMID 15796315. http://archive.rubicon-foundation.org/4038.
- ↑ 110.0 110.1 Kaufner, Lutz; von Heymann, Christian; Henkelmann, Anne; Pace, Nathan L; Weibel, Stephanie; Kranke, Peter; Meerpohl, Joerg J; Gill, Ravi (13 August 2020). "Erythropoietin plus iron versus control treatment including placebo or iron for preoperative anaemic adults undergoing non-cardiac surgery". Cochrane Database of Systematic Reviews 2020 (8): CD012451. doi:10.1002/14651858.CD012451.pub2. PMID 32790892.
- ↑ Kotzé, Alwyn; Harris, Andrea; Baker, Charles; Iqbal, Tariq; Lavies, Nick; Richards, Toby; Ryan, Kate; Taylor, Craig et al. (November 2015). "British Committee for Standards in Haematology Guidelines on the Identification and Management of Pre-Operative Anaemia". British Journal of Haematology 171 (3): 322–331. doi:10.1111/bjh.13623. PMID 26343392.
- ↑ Kassebaum, Nicholas J.; ((GBD 2013 Anemia Collaborators )) (2016). "The Global Burden of Anemia". Hematology/Oncology Clinics of North America 30 (2): 247–308. doi:10.1016/j.hoc.2015.11.002. PMID 27040955.
- ↑ van Hensbroek, MB; Jonker, F; Bates, I (September 2011). "Severe acquired anaemia in Africa: new concepts.". British Journal of Haematology 154 (6): 690–5. doi:10.1111/j.1365-2141.2011.08761.x. PMID 21707575.
- ↑ Abuga, KM; Muriuki, JM; Williams, TN; Atkinson, SH (22 September 2020). "How Severe Anaemia Might Influence the Risk of Invasive Bacterial Infections in African Children". International Journal of Molecular Sciences 21 (18): 6976. doi:10.3390/ijms21186976. PMID 32972031.
- ↑ "Anemia, genetic diseases, and malaria in prehistoric mainland Southeast Asia". American Journal of Physical Anthropology 101 (1): 11–27. September 1996. doi:3.0.CO;2-G">10.1002/(SICI)1096-8644(199609)101:1<11::AID-AJPA2>3.0.CO;2-G. PMID 8876811.
External links
- WHO fact sheet on anaemia
- Anemia, U.S. National Library of Medicine
| Classification | D
|
|---|---|
| External resources |
|
[About Anemia]
 |
Categories: [Anemias] [Wikipedia medicine articles ready to translate] [Transfusion medicine]
↧ Download as ZWI file | Last modified: 05/29/2025 21:59:56 | 4 views
☰ Source: https://handwiki.org/wiki/Medicine:Anemia | License: CC BY-SA 3.0

 KSF
KSF